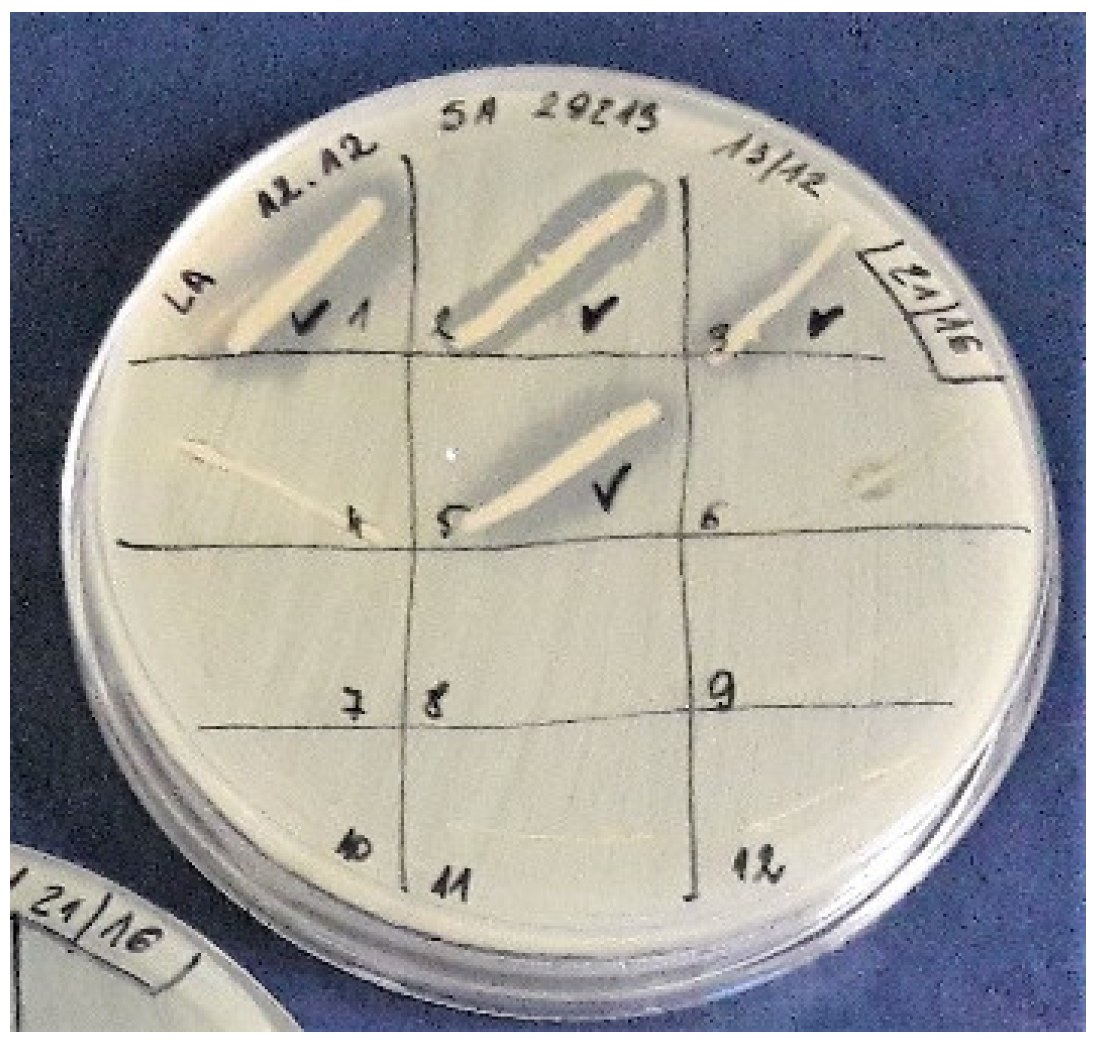
Ijerph 15 02002 g001

The Antimicrobial Potential of Bacteria Isolated from Honey Samples Produced in the Apiaries Located in Pomeranian Voivodeship in Northern Poland
Abstract
1. Introduction
2. Materials and Methods
2.1. Honey Samples and Isolation of Bacterial Strains
2.2. Growth Inhibitory Assay
2.3. The Identification of Bacterial Species Producing Antibacterial Metabolites
- rP1 5’ CCCGGGATCCAAGCTTAGAGTTTGATCCTGGCTCAG 3’
- fD2 5’ CCGAATTCGTCGACAACACGGCTACCTTGTTACGACTT 3’
2.4. DNA Sequence Analysis
2.5. Genetic Differentiation of Producing Strains
3. Results
3.1. Bacterial Content in Honeys and Isolation of Producing Strains
3.2. Species Identification and Genetic Differentiation of “Producing” Strains
4. Discussion
Future Research Directions
5. Conclusions
Author Contributions
Funding
Acknowledgments
Conflicts of Interest
References
- Samarghandian, S.; Farkhondeh, T.; Samini, F. Honey and health: A review of recent clinical research. Pharmacognosy Res. 2017, 9, 121–127. [Google Scholar] [PubMed]
- Molan, P.; Rhodes, T. Honey: A biologic wound dressing. Wounds Compend. Clin. Res. Pract. 2015, 27, 141–151. [Google Scholar]
- Brudzynski, K.; Sjaarda, C. Honey glycoproteins containing antimicrobial peptides, jelleins of the major royal jelly protein 1, are responsible for the cell wall lytic and bactericidal activities of honey. PLoS ONE 2015, 10, e0120238. [Google Scholar] [CrossRef] [PubMed]
- Grecka, K.; Kuś, P.M.; Worobo, R.W.; Szweda, P. Study of the anti-staphylococcal potential of honeys produced in Northern Poland. Molecules 2018, 23, 260. [Google Scholar] [CrossRef] [PubMed]
- Kwakman, P.H.S.; Zaat, S.A.J. Antibacterial components of honey. IUBMB Life 2011, 64, 48–55. [Google Scholar] [CrossRef] [PubMed]
- Brudzynski, K.; Miotto, D.; Kim, L.; Sjaarda, C.; Maldonado-Alvarez, L.; Fukś, H. Active macromolecules of honey form colloidal particles essential for honey antibacterial activity and hydrogen peroxide production. Sci. Rep. 2017, 7, 7637. [Google Scholar] [CrossRef] [PubMed]
- Brudzynski, K.; Abubaker, K.; Miotto, D. Unraveling a mechanism of honey antibacterial action: Polyphenol/H2O2-induced oxidative effect on bacterial cell growth and on DNA degradation. Food Chem. 2012, 133, 329–336. [Google Scholar] [CrossRef] [PubMed]
- Santana, W.C.; Salgado-Silva, M.; Rabadzhiev, Y.; Eller, M.; Ivanova, I.; Iliev, I. Microorganisms in Honey. In Honey Analysis; Arnaut De Toledo, V., Ed.; InTech: Rijeka, Croatia, 2017. [Google Scholar]
- Gilliam, M.; Morton, H.L. Bacteria belonging to the genus Bacillus isolated from honey bees, Apis mellifera, fed 2,4-d and antibiotics (1). Apidologie 1978, 9, 213–222. [Google Scholar] [CrossRef]
- Ahn, J.-H.; Hong, I.-P.; Bok, J.-I.; Kim, B.-Y.; Song, J.; Weon, H.-Y. Pyrosequencing analysis of the bacterial communities in the guts of honey bees Apis cerana and Apis mellifera in Korea. J. Microbiol. 2012, 50, 735–745. [Google Scholar] [CrossRef] [PubMed]
- Wang, M.; Zhao, W.Z.; Xu, H.; Wang, Z.W.; He, S.Y. Bacillus in the guts of honey bees (Apis mellifera; Hymenoptera: Apidae) mediate changes in amylase values. Eur. J. Entomol. 2015, 112, 619–624. [Google Scholar] [CrossRef]
- Filannino, P.; di Cagno, R.; Addante, R.; Pontonio, E.; Gobbetti, M. Metabolism of fructophilic lactic acid bacteria isolated from the Apis mellifera L. bee gut: Phenolic acids as external electron acceptors. Appl. Environ. Microbiol. 2016, 82, 6899–6911. [Google Scholar] [CrossRef] [PubMed]
- Rangberg, A.; Mathiesen, G.; Amdam, G.V.; Diep, D.B. The paratransgenic potential of Lactobacillus kunkeei in the honey bee Apis mellifera. Benef. Microbes 2015, 6, 513–523. [Google Scholar] [CrossRef] [PubMed]
- Kačániová, M.; Pavličová, S.; Haščík, P.; Kociubinski, G.; Kńazovická, V.; Sudzina, M.; Sudzinová, J.; Fikselová, M. Microbial communities in bees, pollen and honey from Slovakia. Acta Microbiol. Immunol. Hung. 2009, 56, 285–295. [Google Scholar] [CrossRef] [PubMed]
- Naseer, S.; Khan, S.A.; Kamran, A.M. Identification of cultivable bacteria from natural honey of different botanical origin. J. Biochem. Mol. Biol 2015, 48, 53–56. [Google Scholar]
- Snowdon, J.A.; Cliver, D.O. Microorganisms in honey. Int. J. Food Microbiol. 1996, 31, 1–26. [Google Scholar] [CrossRef]
- Kuś, P.M.; Szweda, P.; Jerković, I.; Tuberoso, C.I.G. Activity of Polish unifloral honeys against pathogenic bacteria and its correlation with colour, phenolic content, antioxidant capacity and other parameters. Lett. Appl. Microbiol. 2015, 62, 269–276. [Google Scholar] [CrossRef] [PubMed]
- Esawy, M.A.; Ahmed, E.F.; Helmy, W.A.; Mansour, N.M.; El-Senousy, W.M.; El-Safty, M.M. Antiviral Levans from Bacillus spp. Isolated from Honey. In The Complex World of Polysaccharides, 1st ed.; Karunaratne, D.N., Ed.; In Tech: Rijeka, Croatia, 2012; pp. 197–214. ISBN 978-953-51-0819-1. [Google Scholar]
- Aween, M.M.; Hassan, Z.; Muhialdin, B.J.; Noor, H.M.; Eljamel, Y.A. Evaluation on antibacterial activity of Lactobacillus acidophilus strains isolated from honey. Am. J. Appl. Sci. 2012, 9, 807–817. [Google Scholar] [CrossRef]
- Sultana, T.; Rana, J.; Chakraborty, S.R.; Das, K.K.; Rahman, T.; Noor, R. Microbiological analysis of common preservatives used in food items and demonstration of their in vitro anti-bacterial activity. Asian Pacific J. Trop. Dis. 2014, 4, 452–456. [Google Scholar] [CrossRef]
- Mohan, A.; Quek, S.-Y.; Gutierrez-Maddox, N.; Gao, Y.; Shu, Q. Effect of honey in improving the gut microbial balance. Food Qual. Saf. 2017, 1, 107–115. [Google Scholar] [CrossRef]
- Yang, S.-C.; Lin, C.-H.; Sung, C.; Fang, J.-Y. Antibacterial activities of bacteriocins: Application in foods and pharmaceuticals. Front. Microbiol. 2014, 5, 241. [Google Scholar] [PubMed]
- Weisburg, W.G.; Barns, S.M.; Pelletier, D.A.; Lane, D.J. 6S Ribosomal DNA amplification for phylogenetic study. J. Bacteriol. 1991, 173, 697–703. [Google Scholar] [CrossRef] [PubMed]
- Bucekova, M.; Sojka, M.; Valachova, I.; Martinotti, S.; Ranzato, E.; Szep, Z.; Majtan, V.; Klaudiny, J.; Majtan, J. Bee-derived antibacterial peptide, defensin-1, promotes wound re-epithelialisation in vitro and in vivo. Sci. Rep. 2017, 7, 7340. [Google Scholar] [CrossRef] [PubMed]
- Azonwade, F.E.; Paraïso, A.; Agbangnan Dossa, C.P.; Dougnon, V.T.; N’Tcha, C.; Mousse, W.; Baba-Moussa, L. Physicochemical characteristics and microbiological quality of honey produced in Benin. J. Food Qual. 2018, 2018, 1896057. [Google Scholar] [CrossRef]
- Wesołowska, M.; Kačániová, M.; Dżugan, M. The antioxidant properties and microbiological quality of polish honeys. J. Microbiol. Biotechnol. Food Sci. 2014, 3, 422–425. [Google Scholar]
- Fernández, L.A.; Ghilardi, C.; Hoffmann, B.; Gallez, L. Microbiological analysis of honey obtained from various processing points in honey houses of the Pampas Region, Argentina. Rev. Argent. Microbiol. 2015, 49, 55–61. [Google Scholar]
- Różańska, H. Microbiological Quality of Polish Honey. Bull. Vet. Inst. Pulawy 2011, 55, 443–445. [Google Scholar]
- Lee, H.; Churey, J.J.; Worobo, R.W. Antimicrobial activity of bacterial isolates from different floral sources of honey. Int. J. Food Microbiol. 2008, 126, 240–244. [Google Scholar] [CrossRef] [PubMed]
- Lee, S.K.; Lee, H. Antimicrobial activity of solvent fractions and bacterial isolates of Korean domestic honey from different floral sources. Food Sci. Biotechnol. 2016, 25, 1507–1512. [Google Scholar] [CrossRef]
- Abdel Wahab, W.A.; Saleh, S.A.A.; Karam, E.A.; Mansour, N.M.; Esawy, M.A. Possible correlation among osmophilic bacteria, levan yield, and the probiotic activity of three bacterial honey isolates. Biocatal. Agric. Biotechnol. 2018, 14, 386–394. [Google Scholar] [CrossRef]
- Ibarguren, C.; Raya, R.R.; Apella, M.C.; Audisio, M.C. Enterococcus faecium isolated from honey synthesized bacteriocin-like substances active against different Listeria monocytogenes strains. J. Microbiol. 2010, 48, 44–52. [Google Scholar] [CrossRef] [PubMed]
- López, A.C.; Alippi, A.M. Phenotypic and genotypic diversity of Bacillus cereus isolates recovered from honey. Int. J. Food Microbiol. 2007, 117, 175–184. [Google Scholar] [CrossRef] [PubMed]
- Sinacori, M.; Francesca, N.; Alfonzo, A.; Cruciata, M.; Sannino, C.; Settanni, L.; Moschetti, G. Cultivable microorganisms associated with honeys of different geographical and botanical origin. Food Microbiol. 2014, 38, 284–294. [Google Scholar] [CrossRef] [PubMed]
- Iurlina, M.O.; Fritz, R. Characterization of microorganisms in Argentinean honeys from different sources. Int. J. Food Microbiol. 2005, 105, 297–304. [Google Scholar] [CrossRef] [PubMed]
- Wen, Y.; Wang, L.; Jin, Y.; Zhang, J.; Su, L.; Zhang, X.; Zhou, J.; Li, Y. The microbial community dynamics during the vitex honey ripening process in the honeycomb. Front. Microbiol. 2017, 8, 1649. [Google Scholar] [CrossRef] [PubMed]
- Salazar-Marroquín, E.L.; Galán-Wong, L.J.; Moreno-Medina, V.R.; Reyes-López, M.Á.; Pereyra-Alférez, B. Bacteriocins synthesized by Bacillus thuringiensis: Generalities and potential applications. Rev. Med. Microbiol. 2016, 27, 95–101. [Google Scholar] [CrossRef] [PubMed]
- Vázquez-Quiñones, C.R.; Moreno-Terrazas, R.; Natividad-Bonifacio, I.; Quiñones-Ramírez, E.I.; Vázquez-Salinas, C. Microbiological assessment of honey in México. Rev. Argent. Microbiol. 2018, 50, 75–80. [Google Scholar] [CrossRef] [PubMed]
- Shu, L.-J.; Yang, Y.-L. Bacillus classification based on matrix-assisted laser desorption ionization time-of-flight mass spectrometry—Effects of culture conditions. Sci. Rep. 2017, 7, 15546. [Google Scholar] [CrossRef] [PubMed]

| Honey Sample | No. of Colonies per Plate | CFU/ mL of the Product | Activity against S. aureus ATCC 25923 | Activity against S. aureus ATCC 29213 | Activity against S. epidermidis ATCC 12228 | Activity against E. coli ATCC 25922 | Activity against P. aeruginosa ATCC 27857 | Activity against C. albicans ATCC 10231 | Activity against L. momocytogenes ATCC 7644 | |||||||
|---|---|---|---|---|---|---|---|---|---|---|---|---|---|---|---|---|
| No. of Colonies | (%) | No. of Colonies | (%) | No. of Colonies | (%) | No. of Colonies | (%) | No. of Colonies | (%) | No. of Colonies | (%) | No. of Colonies | (%) | |||
| 3/16 | 17 | 34 | 5 | 29.41 | 3 | 17.65 | 6 | 35.29 | 0 | 0 | 0 | 0 | 2 | 11.76 | 1 | 5.88 |
| 21/16 | 3136 * | 3272 | 5 | 25.00 | 4 | 20.00 | 0 | 0 | 1 | 5.00 | 0 | 0 | 3 | 15.00 | 0 | 0 |
| 24/16 | 1520 * | 3040 | 0 | 0 | 0 | 0 | 0 | 0 | 0 | 0 | 0 | 0 | 0 | 0 | 1 | 5.00 |
| 26/16 | 3 | 6 | 1 | 33.33 | 1 | 33.33 | 1 | 33.33 | 0 | 0 | 3 | 100 | 0 | 0 | 1 | 33.33 |
| 28/16 | 25 | 50 | 0 | 0 | 0 | 0 | 1 | 4.00 | 0 | 0 | 0 | 0 | 0 | 0 | 0 | 0 |
| GBY-GR1 | 22 | 44 | 4 | 18.18 | 3 | 13.65 | 6 | 27.27 | 1 | 4.55 | 0 | 0 | 2 | 9.09 | 7 | 31.82 |
| J.K/2018 | 4 | 8 | 0 | 0 | 0 | 0 | 0 | 0 | 0 | 0 | 0 | 0 | 0 | 0 | 3 | 75.00 |
| NGR1 | 173 * | 346 | 13 | 65.00 | 13 | 65.00 | 14 | 70.00 | 0 | 0 | 0 | 0 | 0 | 0 | 18 | 10.40 |
| SH2 | 5 | 10 | 2 | 40.00 | 2 | 40.00 | 1 | 20.00 | 0 | 0 | 0 | 0 | 1 | 20.00 | 2 | 40.00 |
| Spa01 | 9 | 18 | 4 | 44.44 | 2 | 22.22 | 5 | 55.56 | 0 | 0 | 0 | 0 | 0 | 0 | 1 | 11.11 |
| St01 | 1 | 2 | 1 | 100 | 1 | 100 | 1 | 100 | 0 | 0 | 0 | 0 | 0 | 0 | 0 | 0 |
| WLK | 17 | 34 | 3 | 17.65 | 4 | 23.53 | 6 | 35.29 | 0 | 0 | 0 | 0 | 5 | 29.41 | 0 | 0 |
| Total | 38 | 33 | 41 | 2 | 3 | 13 | 34 | |||||||||
| Sample | Honey Source | BLAST | Exhibited Activity | ||||||
|---|---|---|---|---|---|---|---|---|---|
| S. aureus ATCC 25923 | S. aureus ATCC 29213 | S. epidermidis ATCC 12228 | E. coli ATCC 25922 | P. aeruginosa ATCC 27857 | C. albicans ATCC 10231 | L. monocytogenes ATCC 7644 | |||
| 3_16_1 | multiflower | Bacillus sp. (pumilus) | + | + | + | − | − | + | − |
| 3_16_4 | multiflower | Bacillus sp. (pumilus) | + | − | + | − | − | + | − |
| 3_16_13 | multiflower | Bacillus sp. (pumilus/safensis/australimaris)/Microbacterium hydrocarbonoxydans | + | + | + | − | − | − | − |
| 3_16_15 | multiflower | Bacillus sp. (licheniformis) | − | − | + | − | − | − | + |
| 3_16_17 | multiflower | Bacillus sp. (pumilus) | + | − | + | − | − | − | − |
| 21_16_1 | multiflower | Bacillus sp. (pumilus) | + | + | − | − | − | − | − |
| 21_16_2 | multiflower | Bacillus sp. (pumilus/altitudinis/xiamenensis) | + | + | − | − | − | + | − |
| 21_16_3 | multiflower | Bacillus sp. (pumilus/safensis/zhangzhouensis) | + | + | − | − | − | − | − |
| 21_16_4 | multiflower | Bacillus sp. (pumilus/altitudinis/xiamenensis) | + | − | − | − | − | + | − |
| 21_16_5 | multiflower | Bacillus sp. (pumilus) | + | + | − | − | − | + | − |
| 21_16_6 | multiflower | Peanibacillus sp. | − | − | − | + | − | − | − |
| 24_16_4 | multiflower | Staphylococcus sp. | − | − | − | − | − | − | + |
| 26_16_3 | multiflower | Staphylococcus sp. (pasteuri) | − | − | − | − | + | − | − |
| 28_16_5 | multiflower | Microbacterium sp. | − | − | + | − | − | − | − |
| GBY_GR1 | buckwheat | Bacillus sp. (amyloliqefaciens/valezensis/aryabhattai) | + | + | + | − | − | − | − |
| GBY_GR1_2 | buckwheat | Bacillus sp. (subtilis) | + | + | + | − | − | − | − |
| GBY_GR1_5 | buckwheat | Bacillus sp. (aryabhattai/megaterium) | − | − | + | − | − | − | − |
| GBY_GR1_11 | buckwheat | Lysinibacillus sp. (xylanilyticus) | − | − | − | − | − | − | + |
| GBY_GR1_12 | buckwheat | Bacillus sp. (licheniformis) | − | − | − | − | − | − | + |
| GBY_GR1_13 | buckwheat | Peanibacillus sp. | − | − | + | + | − | − | + |
| GBY_GR1_16 | buckwheat | Lysinibacillus sp. (fusiformis) | − | − | − | − | − | − | + |
| GBY_GR1_19 | buckwheat | Bacillus sp. (licheniformis) | − | − | − | − | − | − | + |
| GBY_GR1_21 | buckwheat | Bacillus sp. (pumilus) | + | + | + | − | − | + | − |
| GBY_GR1_22 | buckwheat | Bacillus sp. (pumilus/safensis/zhangzhouensis) | + | − | + | − | − | + | − |
| JK2_18 | multiflower | Bacillus sp. (licheniformis) | − | − | − | − | − | − | + |
| JK3_18 | multiflower | Bacillus sp. (licheniformis) | − | − | − | − | − | − | + |
| NGR1_2 | buckwheat | Bacillus sp. (licheniformis) | − | − | − | − | − | − | + |
| NGR1_3 | buckwheat | Bacillus sp. (kochii) | − | − | + | − | − | − | + |
| NGR1_4.1 | buckwheat | Bacillus sp. (pumilus) | + | + | + | − | − | − | + |
| NGR1_4.5 | buckwheat | Bacillus sp. (pumilus/safensis/zhangzhouensis) | + | + | + | − | − | − | + |
| NGR1_4.10 | buckwheat | Bacillus sp. (pumilus/safensis/zhangzhouensis) | + | + | + | − | − | − | + |
| NGR1_7 | buckwheat | Lysinibacillus sp. | + | − | − | − | − | − | + |
| NGR1_8 | buckwheat | Bacillus sp. (pumilus) | + | + | + | − | − | − | − |
| NGR1_9 | buckwheat | Bacillus sp. (valezensis/tequilensis) | − | + | + | − | − | − | − |
| NGR1_10 | buckwheat | Bacillus sp. (licheniformis/aerius) | − | − | − | − | − | − | + |
| NGR1_12 | buckwheat | Bacillus sp. (licheniformis) | − | − | − | − | − | − | + |
| NGR1_13 | buckwheat | Bacillus sp. (licheniformis) | − | − | − | − | − | − | + |
| NGR1_14 | buckwheat | Peanibacillus sp./Bacillus sp. | − | − | − | − | − | − | + |
| SH2_1 | multiflower | Bacillus sp. (pumilus/altitudinis/xiamenensis) | + | + | − | − | − | + | − |
| SH2_3 | multiflower | Bacillus sp. (amyloliqefaciens/subtilis/valezensis/aryabhattai) | + | + | + | − | − | − | − |
| SH2_4 | multiflower | Bacillus sp. (licheniformis) | − | − | − | − | − | − | + |
| Spa_01_5 | honeydew | Bacillus sp. (pumilus/ altitudinis/xiamenensis) | + | + | + | − | − | − | − |
| St 01 | multiflower | Bacillus sp. (pumilus/zhangzhouensis) | + | + | + | − | − | − | − |
| WLK1_3 | multiflower | Bacillus sp. (pumilus/altitudinis/xiamenensis) | − | + | − | − | − | − | − |
| WLK1_7 | multiflower | Bacillus sp. (pumilus) | + | + | + | − | − | + | − |
| WLK1_15 | multiflower | Bacillus sp. (pumilus) | − | − | + | − | − | + | − |
© 2018 by the authors. Licensee MDPI, Basel, Switzerland. This article is an open access article distributed under the terms and conditions of the Creative Commons Attribution (CC BY) license (http://creativecommons.org/licenses/by/4.0/).
Share and Cite
Pajor, M.; Worobo, R.W.; Milewski, S.; Szweda, P. The Antimicrobial Potential of Bacteria Isolated from Honey Samples Produced in the Apiaries Located in Pomeranian Voivodeship in Northern Poland. Int. J. Environ. Res. Public Health 2018, 15, 2002. https://doi.org/10.3390/ijerph15092002
Pajor M, Worobo RW, Milewski S, Szweda P. The Antimicrobial Potential of Bacteria Isolated from Honey Samples Produced in the Apiaries Located in Pomeranian Voivodeship in Northern Poland. International Journal of Environmental Research and Public Health. 2018; 15(9):2002. https://doi.org/10.3390/ijerph15092002
Chicago/Turabian StylePajor, Magdalena, Randy W. Worobo, Sławomir Milewski, and Piotr Szweda. 2018. "The Antimicrobial Potential of Bacteria Isolated from Honey Samples Produced in the Apiaries Located in Pomeranian Voivodeship in Northern Poland" International Journal of Environmental Research and Public Health 15, no. 9: 2002. https://doi.org/10.3390/ijerph15092002
APA StylePajor, M., Worobo, R. W., Milewski, S., & Szweda, P. (2018). The Antimicrobial Potential of Bacteria Isolated from Honey Samples Produced in the Apiaries Located in Pomeranian Voivodeship in Northern Poland. International Journal of Environmental Research and Public Health, 15(9), 2002. https://doi.org/10.3390/ijerph15092002

